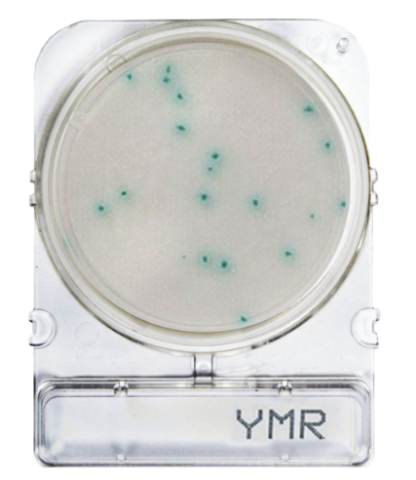
Compact Dry™ YMR  (Rapid) - gotowe do użycia płytki z pożywką do szybkiego oznaczania drożdży i pleśni

Szybkie testy
Kategorie
Producent
Cena
-
od
do
Promocja
Contact Slide 3 (PCA + TTC + Neutralizing / Vogel Johnson Agar) płytki typu dip-slide

Contact Slide 3 (PCA + TTC + Neutralizing / Vogel Johnson Agar) płytki typu dip-slide
• Opakowanie: 20 szt.
• Płytki typu dip-slide
• Przeznaczenie: Ogólna liczba drobnoustrojów (OLD), Staphylococcus
• Substancje neutralizujące: TAK
Contact Slide 2 (PCA+TTC+neutralizing/ROSE BENGAL CAF+neutralizing) płytki typu dip-slide

Contact Slide 2 (PCA+TTC+neutralizing/ROSE BENGAL CAF+neutralizing) płytki typu dip-slide
• Opakowanie: 120 szt.
• Płytki typu dip-slide.
• Przeznaczenie: Ogólna liczba drobnoustrojów (OLD), Drożdże i pleśnie (Y&M)
• Substancje neutralizujące: TAK
Contact Slide 1 (PCA+TTC+neutralizing/VRBG+neutralizing) płytki typu dip-slide

Contact Slide 1 (PCA+TTC+neutralizing/VRBG+neutralizing) płytki typu dip-slide
• Opakowanie: 120 szt.
• Płytki typu dip-slide.
• Przeznaczenie: Ogólna liczba drobnoustrojów (OLD), Enterobacteriaceae
• Substancje neutralizujące: TAK
Compact Dry™ YMR (Rapid) - gotowe do użycia płytki z pożywką do szybkiego oznaczania drożdży i pleśni, op. 240 szt.

Compact Dry™ YMR (Rapid) - gotowe do użycia płytki z pożywką do szybkiego oznaczania drożdży i pleśni, op. 240 szt.
• Opakowanie: 240 szt.
• Do szybkiego oznaczania drożdży i pleśni w 48-72 h
• Do szybkiego oznaczania drożdży i pleśni w 48-72 h
• Yeast & Mold - Rapid
Compact Dry™ YMR (Rapid) - gotowe do użycia płytki z pożywką do szybkiego oznaczania drożdży i pleśni, op. 1400 szt.

Compact Dry™ YMR (Rapid) - gotowe do użycia płytki z pożywką do szybkiego oznaczania drożdży i pleśni, op. 1400 szt.
• Opakowanie: 1400 szt.
• Do szybkiego oznaczania drożdży i pleśni w 48-72 h
• Do szybkiego oznaczania drożdży i pleśni w 48-72 h
• Yeast & Mold - Rapid
Compact Dry™ YMR (Rapid) - gotowe do użycia płytki z pożywką do szybkiego oznaczania drożdży i pleśni
Compact Dry™ YMR (Rapid) - gotowe do użycia płytki z pożywką do szybkiego oznaczania drożdży i pleśni
• Opakowanie: 4 szt.
• Do szybkiego oznaczania drożdży i pleśni w 48-72 h
• Do szybkiego oznaczania drożdży i pleśni w 48-72 h
• Yeast & Mold - Rapid
Compact Dry™ XSA - gotowe do użycia płytki z pożywką chromogenną do oznaczania S.aureus

Compact Dry™ XSA - gotowe do użycia płytki z pożywką chromogenną do oznaczania S.aureus
• Opakowanie: 4 szt.
• Staphylococcus aureus
darmowa i wygodna wysyłka
już od 800 zł netto
Najwyższa jakość
produktów potwierdzona certyfikatami
Zakupy 24h na dobę
wygodne i bezpieczne
bezpłatna konsultacja
z ekspertem online







